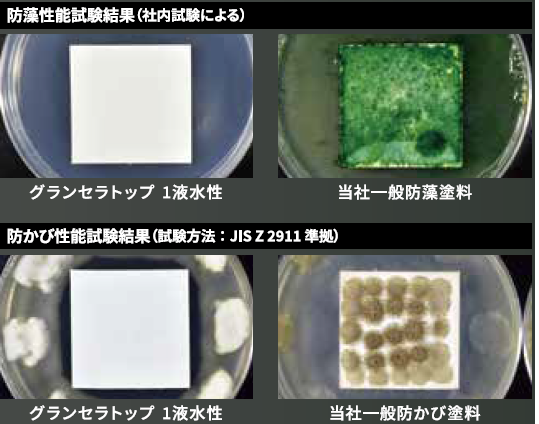

グランセラトップ1液水性とは?耐候性・超低汚染・つやの違いを徹底解説|外壁塗装におすすめの無機ハイブリッド塗料

外壁の美しさを長く保つためには、耐候性や汚れにくさに優れたトップコート選びが欠かせません。「グランセラトップ1液水性」は、ラジカル制御技術と無機ハイブリッド技術を組み合わせた、超高耐候タイプの水性トップコート。美しいつや、高耐久、超低汚染性、防藻・防かび、透湿性など、高い総合性能を備えています。
この記事では、カタログ画像を交えながらグランセラトップ1液水性の特長・性能・おすすめの用途をわかりやすく解説します。
グランセラトップ1液水性とは?

グランセラトップ1液水性は、日本ペイントが独自開発した「ラジカル制御技術」と「セラミックハイブリッド技術」を組み合わせた無機系トップコートです。1液水性のため扱いやすく、外壁の美観を長期間維持できる優れた耐候性が特徴。
期待耐用年数は最大20年。一般的なシリコン・フッ素系塗料を超える、ハイグレード帯の外壁用トップコートです。
セラミックハイブリッド無機系塗料とは?
無機塗料は耐候性が高く丈夫ですが、光沢性や密着性が弱いという課題があります。
そこで、日本ペイントは「無機成分」と「有機成分」をハイブリッド化することで、両者の弱点を補いながら性能を強化しました。

つまりグランセラトップ1液水性は…
- 無機の“耐候性・耐久性”
- 有機の“柔軟性・仕上がりの良さ”
の両方を兼ね備えた高性能ハイブリッド塗料です。
紫外線に強い、非常に優れた耐候性
外壁の劣化原因の多くは「紫外線によるラジカル発生」。
グランセラトップ1液水性は、ラジカル発生を抑制する機能を持った“ラジカルバリアー”を形成し、塗膜の劣化を長期間防ぎます。
期待耐用年数は最大20年
早期退色や劣化を抑制し、外壁を長く守ることができます。

6つの特長”で外壁を美しく守る
①優れた耐候性
促進耐候試験では、高い光沢保持率を記録。
外壁の退色やチョーキングを長期間抑え、きれいな状態を保ちます。
②美しい艶
グランセラトップ1液水性は高いレベリング性により、滑らかで美しいつや感を実現。
- 7分つや
- 5分つや
- 3分つや
- つや消し
など、幅広くつやを選べるのも特徴です。

③超低汚染性
親水性の高い塗膜により、外壁に付着した汚れを雨水と一緒に洗い流す“セルフクリーニング効果”が働きます。
- 黒ずみ
- 雨だれ
- 排気ガス汚れ
などの付着を抑え、長期間美観を維持できます。

④防藻・防かび性能
従来はオプション扱いだった「防藻・防かび機能」を標準搭載。
湿気の多い地域や日陰が多い外壁でも、かびや藻の発生を抑制し、美しさが長持ちします。
⑤透湿性
塗膜に適度な透湿機能があり、外壁内部に溜まった湿気を放出しやすくします。
- 膨れ
- 剥離
などのトラブルを抑える効果があります。
⑥弾性仕様にも対応
弾性下地と組み合わせることで、壁の動きに追従。
クラック(ひび割れ)が起きやすい外壁にも対応しやすく、リフォームにも最適です。
まとめ
グランセラトップ1液水性は、超高耐候性・超低汚染性・美しいつやを兼ね備えた高性能トップコートです。
外壁の美観を長期間維持したい方や、汚れやかびに悩む外壁におすすめ。
ハイグレード塗料として、耐久性を重視した外壁塗装に最適な選択肢といえるでしょう。
Contact
お問い合わせ
外壁塗装が初めてのお客様でも、ご不安なくご依頼いただけるように、専門スタッフが建物の状態を丁寧にチェックし、現在必要な工事のみを分かりやすくご説明いたします。無理な営業や、不要な工事をおすすめすることは一切ありません。お住まいの状況に合わせて、グランセラトップ1液水性の特徴やメリット・デメリットも誠実にお伝えし、お客様にとって最適なプランをご提案いたします。まずはお気軽にご相談ください。



コメント